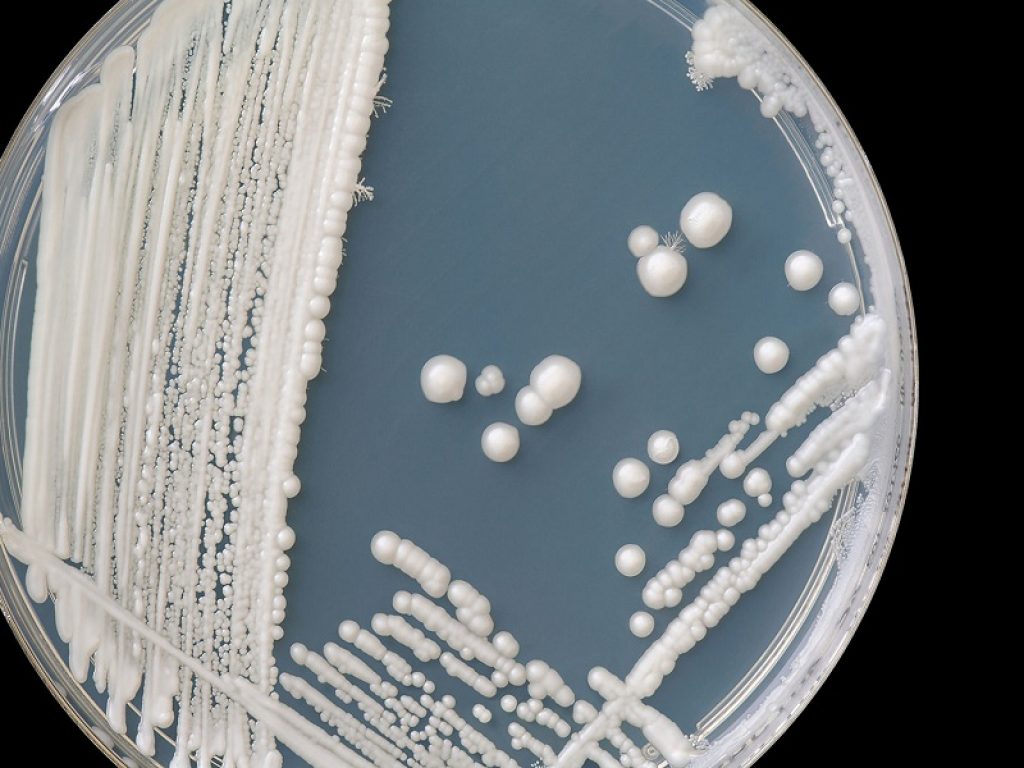
Farmaci e prodotti topici per curare la candida

La candida si può curare con dei farmaci antifungini di tipo orale o locale come creme, ovuli e lavande. Consigliati anche prodotti topici contenenti lattobacilli
Quando si parla di candida in ambito medico ci si riferisce a un’infezione causata da un fungo, chiamato Candida albicans, che normalmente è presente nel tratto gastro-intestinale e genitale (e per questo chiamato “commensale”), ma che, in alcuni casi, può proliferare eccessivamente in sede vulvare e/o vaginale e causare infiammazione.
In alcune donne predisposte, e in seguito ad alcune condizioni, Candida Albicans prolifera dando origine alla candidosi: si stima infatti che i 2/3 delle donne in età fertile abbiano avuto la candida almeno una volta nella vita. Questo fungo si trova anche nel cavo orale: in questo caso, se diventa patologico, si parla di mughetto.
La dottoressa Serena Del Zoppo, ginecologa in Humanitas Medical Care ad Arese, spiega quali occasioni favoriscono lo sviluppo di candidosi e alcuni consigli per prevenire lo svilupparsi di questa infezione.
Che cos’è la candida
La candidosi si manifesta quando il fungo Candida Albicans prolifica più del consueto diventando sintomatico. Nel 4-5% dei casi inoltre la candida può trasformarsi una vaginite ricorrente cronica, cioè un’infezione che si ripresenta più di tre volte all’anno.
Ci sono delle condizioni dell’organismo che possono indurre la sviluppo di candidosi, come per esempio l’immunodeficienza, l’assunzione di una terapia antibiotica, il diabete, la gravidanza oppure ancora l’utilizzo di contraccettivi orali. Le infezioni da candida possono colpire sia le donne che gli uomini.
Quali sono i sintomi della candida
Nelle donne la candida provoca l’arrossamento delle mucose genitali, prurito intimo e irritazione, secrezioni vaginali biancastre, odorose e dense. In alcuni casi può anche essere causa di dolore durante i rapporti sessuali e bruciore alla minzione.
Negli uomini invece si riconosce poiché provoca un’eruzione cutanea e l’arrossamento del glande, a volte accompagnato da bruciore. Questa condizione in alcuni casi può allargarsi al prepuzio, che può anche manifestare la fuoriuscita di perdite biancastre. La sintomatologia negli uomini si presenta frequentemente dopo un rapporto sessuale.
Come si previene la candida?
Per prevenirla è importante una corretta igiene intima che faccia uso di detergenti acidi (con un valore del Ph intorno al 4). Inoltre l’utilizzo di biancheria sintetica e troppo aderente in alcune donne predisposte può rappresentare un fattore scatenante; infatti, se l’intimo utilizzato non permette un’adeguata traspirazione dei tessuti può favorire la proliferazione dei germi. Anche forti o prolungati periodi di stress rappresentano un fattore di rischio.
Un’altra condizione che può far insorgere la candida è la terapia antibiotica: questa danneggia i lattobacilli, che rappresentano la flora batterica vaginale deputata alla difesa della vagina. Insieme alla terapia antibiotica si consiglia quindi l’utilizzo di fermenti lattici per via orale e/o vaginale.
Anche un’alta percentuale di zuccheri nel sangue, che può verificarsi per esempio nelle pazienti diabetiche o in chi ha una dieta particolarmente ricca di carboidrati, crea un macrosistema che favorisce il proliferare di questo fungo. Al contrario, un’alimentazione sana accompagnata da un adeguato consumo di acqua aiuta la corretta funzionalità intestinale, che evita a sua volta il ristagno di germi patogeni nell’ambiente vaginale.
La candida infine si può trasmettere per via sessuale, anche se non deve essere considerata una malattia a trasmissione sessuale nel vero senso della parola. Anche l’uso di asciugamani o indumenti usati da una persona infetta può far contrarre la candida.
Come curare la candida
Una volta diagnosticata (spesso con una semplice ispezione vaginale durante la visita ginecologica o con un tampone vaginale nelle donne o con un tampone uretrale negli uomini) la candida si può curare con dei farmaci antifungini, di tipo orale o locale (creme, ovuli e lavande). Prodotti topici contenenti lattobacilli aiutano inoltre a ripristinare una corretta flora batterica vaginale. Nel caso l’infezione interessi entrambi i partner è necessario che la cura interessi entrambi, per evitare il cosiddetto “effetto ping-pong”.
La cura per la candida ha la funzione di bloccare l’infezione, ma non elimina la presenza del fungo dall’organismo, che come abbiamo visto, è naturale; per questa ragione però non si può escludere che l’infezione si manifesti nuovamente.